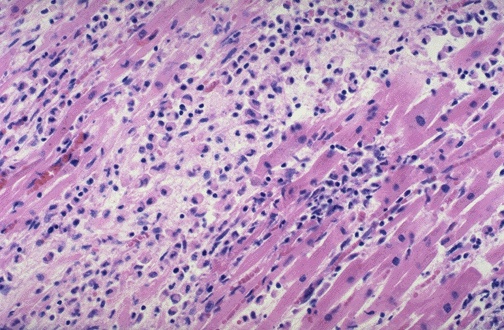

| Here is an example of a florid myocarditis. This myocarditis consists mainly of mononuclear cells, but is mixed with some scattered PMN's as well. The pattern was that of a patchy myocarditis. In this case the inflammation was due to disseminated toxoplasmosis from Toxoplasma gondii infection. |
![]() |